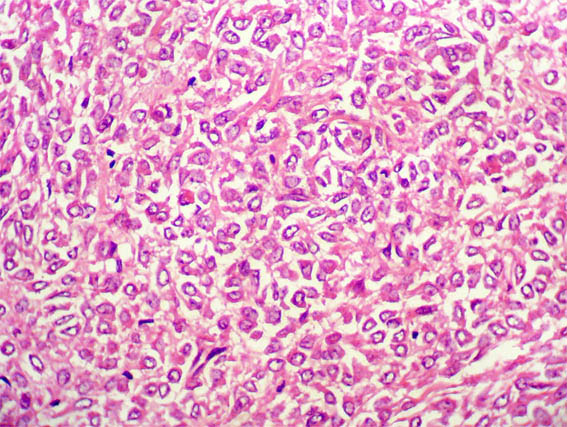

Caso
67 Con discusión |
English
version |
|||
CASO 67 (Septiembre 2011)
Datos clínicos:
Mujer de 49 años en quien detectan una masa de 4,2 cm en el polo superior del riñón izquierdo. Hacen nefrectomía. La masa se describe como una lesión sólida, intrarrenal, con limites bien definidos, aunque no encapsulada, y sin compromiso del hilio. No se describen otras lesiones en el órgano.
Este caso fue recibido para interconsulta y no disponemos de imágenes macroscópicas.
Observe el aspecto histológico y la inmunohistoquímica.

Figura 1. H&E, X100.

Figura 2. H&E, X200.

Figura 3. H&E, X400.

Figura 4. H&E, X200.
Figura 5. H&E, X400.

Figura 6. Inmunohistoquímica (IHQ) para cocktail de citoqueratinas, X400.

Figura 7. IHQ para actina de músculo liso, X400.

Figura 8. IHQ para CD34, X400.

Figura 9. IHQ para HMB-45, X400.

Figura 10. IHQ para Ki67, X400. Ídice proliferativo de 1%.

Figura 1. IHQ negativa para ALK1, Desmina y EMA. Positividad focal para S-100. Todas X400.
¿Cuál es su diagnóstico?